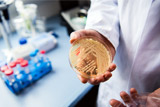

НОВОСТИ ПО ТЭГУ
→Счетная палата

Культура —
Большой театр изменит схему продажи билетов после замечаний Счетной палаты
Учреждение сократит на 30% бронь билетов на спектакли в первый день предварительной продажиСчетная палата обвинила Росавиацию в срыве сроков реконструкции "Домодедово"
В процессе модернизации пропускная способность аэропорта упала на 35%Счетная палата не нашла в бюджете следов Фонда развития и "инфраструктурной ипотеки"
Глава ведомства Антон Кудрин предложил Госдуме разобраться, куда уйдут выделенные на Фонд деньгиВ России —
75% нарушений в госзакупках в 2018 году пришлись на обоснование начальной цены контракта
Счетная палата выявила нарушения на общую сумму в размере около 220 млрд рублейВ России —
Счетная палата напомнила Минздраву о выполнении "майского указа" за счет сокращений
По статистике, зарплаты медиков в 2018 году росли одновременно с их сокращениями, говорят аудиторыСкворцова назвала почти выполненной статью майского указа о зарплатах медикам
По словам главы Минздрава, недавний доклад Счетной палаты неправильно интерпретировали"Майский указ" по зарплатам медработников не выполнили более половины регионов
Об этом Счетная палата заявила по итогам проверки Минздрава и других учреждений за 2018 год
Потери казны из-за передачи "Роскапитала" корпорации ДОМ.РФ составили 80,5 млрд рублей
Счетная палата в этом видит риски невыполнения одной из задач нацпроекта "Жилье и городская среда"
В России —
Счетная палата РФ назвала недостижимыми цели по снижению бедности на 2019 год
Согласно докладу, в первом квартале реальные располагаемые доходы населения уменьшились на 2,3% к 2018 году
В России —
Счетная палата сочла госсподдержку молодых ученых неэффективной
Термин "молодой ученый" - слишком размытый, поэтому сложно определить даже достоверный объем финансирования
В России —
Кудрин посоветовал россиянам интересоваться, куда уходят деньги
Глава Счетной палаты считает, что у граждан нет "чувства налогоплательщика"
В России —
Кудрин увидел в аресте Калви невыполнение установок президента
Глава Счетной палаты также опроверг сообщения о том, что он стал поручителем за американского предпринимателя
В России —
Счетная палата не поддержала законопроект об устойчивом Рунете
В официальном отзыве на проект говорится, что его реализация приведет к росту цен на российском рынке
В России —
Счетная палата обвинила Росалкогольрегулирование в недостаточном контроле продукции
Проверка за три года выявила, в частности, нарушения при конкурсах по госконтрактам
Кудрин перечислил риски для российской экономики
По его словам, в частности, это нефтяные цены, санкции, уменьшение числа трудоспособных граждан и отсутствие структурных реформ
Кудрин заявил, что российская экономика попала в "застойную яму"
По словам главы Счетной палаты, столь продолжительного периода низкого роста не было со времен Второй мировой, за исключением 1990-1998 годовНовости в разделах
Фотогалереи

25
Лучшие снимки животных - 2024

10
Фотохроника 27 декабря

25
Лучшие фото 2024 года

10
Фотохроника 26 декабря

10
Фотохроника 25 декабря

25
Уходящий год в фотографиях

25
Лучшие спортивные фотографии 2024 года

8
Мазут на пляжах Краснодарского края

10
Предновогодняя Москва

12
Саммит БРИКС в Татарстане

9
Обстановка у офиса Wildberries в Москве

10







